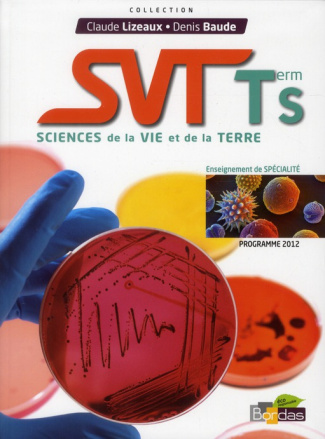
Sciences de la Vie et de la Terre Tle S Enseignement de spécialité. Programme 2012

SVT 2de Programme 2010
Lizeaux Claude ; Baude Denis
BORDAS
32,55 €
Épuisé
EAN :
9782047327586
Présentation de l'éditeur Des documents pour mobiliser rapidement les acquis du collège. De nombreuses activités pratiques pour mener une démarche d'investigation. Pour chaque chapitre, un bilan et des schémas pour mémoriser les connaissances essentielles. Des exercices variés, de difficulté graduée, pour tester connaissances et capacités, remédier aux éventuelles difficultés. Des documents complémentaires pour un accompagnement personnalisé.
Distributor Debug Info
| SKU: | 9782047327586 |
| wmi_id_distributeur: | Not set |
| Is Salable (from plugin): | No (Out of Stock) |
| Is Salable (direct MSI check): | No (Out of Stock) |
| Distributor Name: | Par défaut |
| Availability Value: | 0 |
| Availability Label: | Epuisé |
| Match Result: | |
| Default Availability (Config): | 0 - Epuisé |
| Raw Config Mapping: |
Array
(
[_1772119784121_121] => Array
(
[id] => 12707000
[name] => 12707000
[availability] => 1
[activation_attribute] => 1
)
)
|
Plus d'informations
| EAN | 9782047327586 |
|---|---|
| Titre | SVT 2de Programme 2010 |
| Auteur | Lizeaux Claude ; Baude Denis |
| Editeur | BORDAS |
| Largeur | 181 |
| Poids | 484 |
| Date de parution | 20100803 |
| Nombre de pages | 264,00 € |
Découvrez également
Latin-Grec
Economie
Néerlandais
Histoire - Géo
Anglais
Français
Autres matières
Religion & Morale
Multi-matières
Mathématiques
dans
Scolaire secondaire
Pourquoi choisir Molière ?
Efficacité et rapidité Commandé avant 16h livré demain
Économique et pratique Livraison à domicile dès 5,10 €
Facile et sans frais Retrait gratuit en magasin
Sécurité et tranquillité Paiement 100 % sécurisé
Disponibilité et écoute Contactez-nous sur WhatsApp
Du même auteur
-

SVT 5e. Programme 2010, Edition 2010
Lizeaux Claude ; Baude DenisUne édition conforme au programme actualisé 2010 Des documents en début de chapitre pour mobiliser rapidement les acquis du primaire et de la 6e. Des documents simples pour permettre à tous les élèves d'atteindre les objectifs fixés par les nouveaux textes en vigueur. De nombreuses activités pratiques (observations, expérimentations, manipulations simples à mettre en oeuvre) pour accompagner la démarche d'investigation. Pour chaque chapitre, un bilan des activités accompagné d'un schéma facilitant la mémorisation et l'essentiel des compétences du socle commun. Des exercices totalement nouveaux, de difficulté graduée et comportant des exercices guidés et des QCM. Des supports pour la formation et l'évaluation des compétences du B2i. Des doubles pages consacrées aux thèmes de convergence, axées sur le développement durable et l'éducation à la santé.ÉPUISÉVOIR PRODUIT26,45 € -

Sciences SVT-Physique-Chimie 1re L/ES. Manuel petit format, programme 2011
Lizeaux Claude ; Baude DenisPrésentation de l'éditeur Un manuel simple qui intègre SVT et Physique-Chimie. Un manuel moderne pour un apprentissage motivant des sciences. Unmanuel numérique Premium avec des vidéos, des animations, des fiches documentaires et un nouvel espace de création de cours.ÉPUISÉVOIR PRODUIT32,90 € -
Sciences de la Vie et de la Terre Tle S Enseignement de spécialité. Programme 2012
Lizeaux Claude ; Baude DenisPrésentation de l'éditeur Des manuels en parfaite conformité avec les programmes- Ils visent à la construction d'une culture scientifique fondée sur des connaissances et sur la maîtrise de compétences propres aux sciences. - Motivants, ces manuels participent à la formation d'un esprit critique et préparent efficacement à la poursuite d'études supérieures. - Très nombreux supports pour des activités pratiques à réaliser en classe faisant appel à des méthodes et à des outils différenciés.Des manuels pour les élèves- De nombreux schémas et des schémas-bilan facilitent les apprentissages. - Des pages de culture scientifique proposent certains approfondissements, une ouverture vers le monde de la recherche, les métiers scientifiques, l'art ou encore l'histoire des sciences.Pour le baccalauréat :Des exercices variés préparent aux différentes compétences évaluées au baccalauréat : questions de synthèse, test de connaissances sous la forme de QCM, pratique du raisonnement scientifique, capacités expérimentales.ÉPUISÉVOIR PRODUIT24,20 € -

SVT 5e. Manuel petit format, Programme 2010
Lizeaux Claude ; Baude DenisÉPUISÉVOIR PRODUIT22,90 €
Du même éditeur
-
Dominos des mots
COLLECTIFCes 4 jeux de cartes, dès 4 ans, proposent une approche pédagogique par le jeu, pour découvrir, apprendre ou revoir des notions du programme de l'école primaire : Les syllabes L'histoire , Le code de la route, Les chiffres Chaque jeu reprend un principe de jeu de cartes bien connu des enfants : jeu des 7 familles, dominos, et memory. L'enfant peut donc jouer en toute autonomie, seul ou à plusieurs. L'apprentissage par le jeu stimule la curiosité de l'enfant, suscite son intérêt et est plus motivant. Le jeu de cartes permet ainsi de varier l'approche pédagogique, ce qui rend moins répétitif l'apprentissage.EN STOCKCOMMANDER9,99 € -
Allemand. Vocabulaire thématique
Tard FrançoiseAvez-vous toujours "le mot pour dire"? Ou bien vous arrive-t-il de ne pas trouver les mots allemands pour exprimer votre pensée? L'utilisation d'un vocabulaire thématique est un excellent moyen, le meilleur peut-être, pour retenir les mots appris et en acquérir de nouveaux. En effet, l'association thématique des mots permet de mieux les mémoriser. Avec ses 4000 entrées, LE MOT POUR DIRE s'agrémente d'encadrés proposant remarques, commentaires et expressions, ainsi que d'illustrations pleines d'humour et d'élégance.ÉPUISÉVOIR PRODUIT12,90 €
De la même catégorie
-
ESSENTIA 3 - AGREE - REFERENTIEL SB ET SG. ancienne édition
JACQUES BUSCHEN,JUSTÉPUISÉVOIR PRODUIT26,40 € -
ESSENTIA 3 - AGREE - CAHIER SG ( SCOODLE) ancienne édition
JACQUES BUSCHEN,MARIÉPUISÉVOIR PRODUIT19,65 € -
EXPERTS BIOLOGIE 3 - SCIENCES DE BASE ancienne edition
NOAM DELAISSE,JONASÉPUISÉVOIR PRODUIT10,15 €





